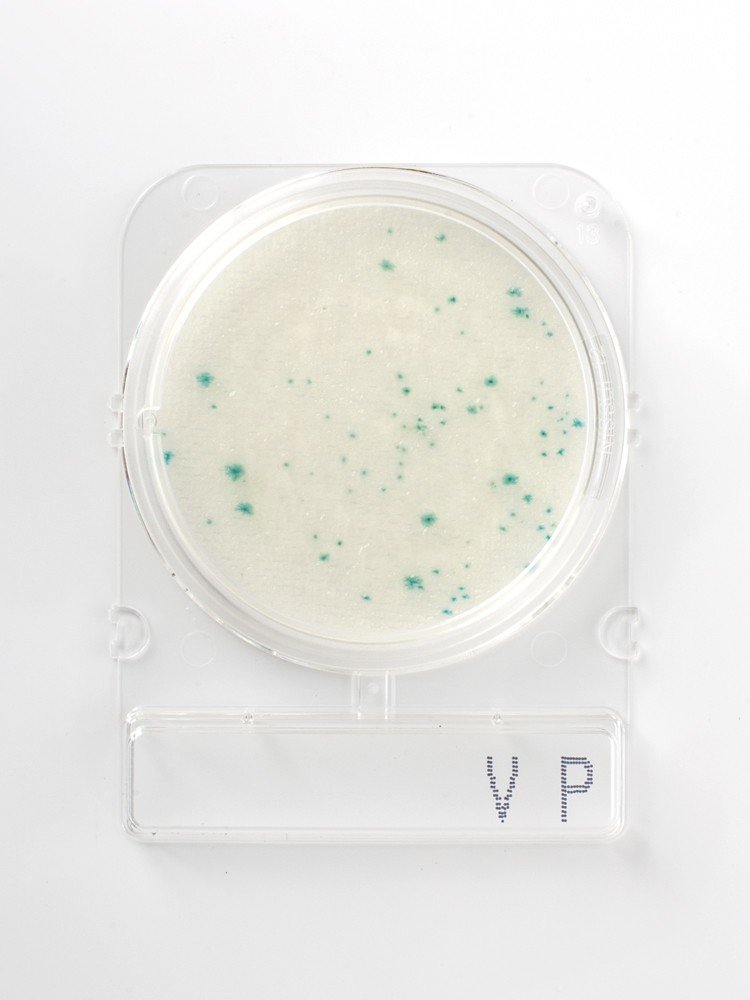

Compact Dry™ Prepared Media Plates - 6749
Compact Dry™ is a simple and safe procedure to determine and quantify microorganisms in food and beverage, raw materials, cosmetics and pharmaceutical industries and internal environmental monitoring. The ready-to-use Compact Dry™ chromogenic plates are suitable for both in-process and final product controls.
- Ready-to-use
- Self-diffusing media - no need for a spreader
- Room temperature storage vs competitive products with storage at temperatures less than or equal to 8ºC
- Rigid transparent plates with removable lid - no leakage
- Innovative stacking design
- Easy to label
- Ability to subculture without damage to colonies
- Widest available parameters and broadest application
- Convenient, fast and accurate results
Vibrio is a gram-negative rod-shaped bacterium that is characterized by a rigid curve, usually motile due to to a unique polar scourge. V. cholerae, V. parahaemolyticus and V. yulniftcus are three known pathogenic species of Vibrio with documented cases. Vibro is commonly found in seawater, as it can tolerate a high salt concentration. Foods that are we contaminate with Vibrio can have negative health consequences, starting with diarrhea and, worse, death. Therefore, it is considered as a release parameter for shellfish and shellfish products.
You've got questions, we've got answers.
Reach out and let's see what we can do together.